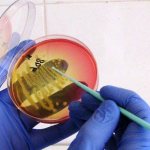
image

Случается, что во время лабораторной диагностики замечают грамотрицательные диплококки в мазке у женщин. Такие результаты не всегда говорят о наличии опасной венерической инфекции. Но и игнорировать такие данные исследования тоже не стоит. Грамотрицательные бактерии имеют тонкую оболочку, поэтому они малоустойчивы к антибиотикам.
В норме микрофлора влагалища женщины состоит из разных бактерий, которые находятся в идеальном количестве. Наличие диплококков в мазке свидетельствует о патологии.
Молочные бактерии продуцируют молочную кислоту, которая является барьером для проникновения патогенных микроорганизмов. В случае снижения уровня кислотности в среде влагалища увеличивается риск появления грамположительных диплококков, и это доказывает нарушение баланса в секрете. Если гонококки будут продолжительное время находиться в женском организме, то это чревато следующими последствиями:
- Могут образовываться спайки в органах малого таза.
- Часто развивается эрозия шейки матки.
- Может развиться эндометрит или вообще отсутствовать эндометрий в полости матки.
Виды диплококков
Для диагностики воспалительных процессов урогенитального тракта у пациентов берут мазки.
В них могут быть выявлены диплококки.
Их наличие может свидетельствовать о гонококковой инфекции.
Но не всегда расположенные парами бактерии – это гонококки.
Есть и другие микроорганизмы, которые могут выглядеть точно так же.
Большинство диплококков не встречаются в мочеполовой системе.
Но они могут выявляться в мазках анальных или орофарингеальных (изо рта).
Это как патогенные, так и сапрофитные бактерии.
В их числе:
- менингококки;
- пневмококки;
- Streptococcus pneumoniae;
- непатогенные нейссерии (Neisseria cinerea и другие).
Некоторые бактерии располагаются не только попарно.
Например, гемофильная палочка.
Бактериальные клетки в мазке могут выявляться отдельные, парные или большими скоплениями (по 3 и больше клетки).
Поэтому в случае обнаружения в мазке у мужчин диплококков не всегда можно ставить диагноз гонорея.
Нужны дополнительные признаки, отличающие его возбудителя от других бактерий.
В противном случае возможна гипердиагностика гонококковой инфекции.
Расположение
Диплококки – полиморфные микроорганизмы. Данные патогенные возбудители могут обитать как внутри клетки, так и циркулировать по всему организму.
С учетом расположения различают две формы диплококков.
Внутриклеточные
Наиболее опасный тип диплококков, что обусловлено их способностью эволюционировать внутри клетки и тем самым адаптироваться к любым изменениям, происходящим в организме.
Репродуцирующиеся диплококки вызывают патологические изменения со стороны органов мочеполовой системы. Выступают в роли источника бактериального заражения, а также, что наиболее серьезно, гонореи и уретрита.
Внеклеточные
Данный вид возбудителя пребывает в покоящейся стадии. Он не имеет внутриклеточного строения, не размножается и не растет. Возбудитель окружен плотной оболочкой, которая защищает его от низких температур, высыхания и излучения.
Несмотря на то, что в норме внеклеточный диплококк обитает в слизистой влагалища женщины в минимальных количествах, он может играть и роль паразита. Возбудитель способен мигрировать по организму и тем самым вызывать патологические процессы во многих органах.
Причины диплококков в мазке
Клиническое значение при взятии мазков из урогенитального тракта имеет только выявление в нем гонококков.
Это возбудители гонореи.
Данная инфекция передается половым путем.
Она вызывает воспалительные процессы уретры.
Может поражать и другие органы.
Нередко распространяется на предстательную железу.
Иногда вызывает воспаление яичек.
У женщин возможны вагиниты, цервициты, воспалительные процессы малого таза.
Причина заражения диплококками – это незащищенный секс.
При половом акте бактерии попадают в уретру.
Там они внедряются в слизистую, а через несколько дней инициируют воспалительные реакции.
5
Профилактика заболевания
Самым частым путем заражения этими бактериями является половой. По этой причине важно исключить беспорядочные сексуальные контакты, пользоваться презервативами и придерживаться правил личной гигиены. Исключить заражение гонококками, менингококками или пневмококками поможет соблюдение следующих рекомендаций:
- отказ от вредных привычек;
- соблюдение правильного питания;
- регулярная смена белья и мытье тела;
- недопущение серьезных нервных истощений;
- укрепление иммунитета;
- использование после опасного полового акта Хлоргексидина или Мирамистина;
- избегать посещения мест с большим скоплением людей во время эпидемий.
Диплококк может попасть в организм через различные органы. Самым распространенным путем заражения является незащищенный половой контакт с носителем бактерии. Для профилактики заболевания мужчина должен соблюдать правила личной гигиены и пользоваться презервативом.
Симптомы если диплококки в мазке
Заболевание сопровождается у мужчин выраженными симптомами.
У пациентов женского пола в 50% случаев они отсутствуют.
В основном развиваются признаки уретрита.
Для диплококков характерно наличие большого количества гнойных выделений.
Мужчины жалуются, что у них капает с пениса.
Одновременно появляются такие признаки:
- инфильтрация уретры (при пальпации она определяется в виде плотного тяжа);
- дискомфорт при мочеиспускании;
- болевые ощущения во время полового акта;
- покраснение меатуса.
Если инфекция распространяется на предстательную железу, отмечается тяжесть в промежности или боль.
Она может иррадиировать в крестец, прямую кишку.
При воспалении яичек и придатков отмечается боль в мошонке.
Возможно её покраснение, сглаживание складчатости.
Из уретры инфекция может распространяться на шейку мочевого пузыря.
Чаще это случается у женщин.
Тогда отмечаются сильные и частые позывы к мочеиспусканию.
Диплококки могут распространяться на влагалище, цервикс, матку и придатки.
Тогда появляется диспареуния, боль в животе, гнойно-геморрагические выделения.
Микрофлора влагалища у женщин
Мазок у мужчин берется из уретры. Если врач обнаружит данный диплококк, пациенту назначается повторная сдача бактериального анализа. Повторный мазок берут при помощи липкой полоски и стекла.
В большинстве случаев наличие в мазке внеклеточных диплококков у мужчины позволяют диагностировать гонорею. Помимо этого они могут являться причиной развития менингита, пневмонии и других опасных заболеваний. У мужчин эти заболевания встречаются чаще из-за беспорядочных половых контактов с непостоянными партнерами.
Симптомы менингита, пневмонии и гонореи следующие.
При менингите у больного:
- Заметна ригидность мышц;
- Он запрокидывает голову назад;
- Подгибает к животу колени;
- Отмечается высокая температура до 40 градусов °C;
- Лихорадка;
- Возможны галлюцинации;
- Рвота;
- Невыносимые головные боли;
- Больной может кричать от боли.
При развитии пневмонии:
- Поднимается высокая температура;
- Кашель;
- Жар;
- Возможны головные боли;
- Тяжесть;
- Одышка и прочее.
При гонореи первые симптомы будут:
- Гнойные выделения из половых путей;
- Общее недомогания;
- Воспаления мочеполовых путей с последующими болями внизу живота;
- Дискомфорт при мочеиспускании.
| Гонококки или венерические возбудители гонореи. | Эти бактерии, проникая в организм, образуют цепочки или бобовидные формы, которые способны вызывать жжение в области уретры во время мочеиспускания. Так же появляются желтые редкие выделения, и они сопровождаются неприятным запахом рыбы. Внутри влагалища такие бактерии могут вызывать нагноения области матки. |
| Менингококковые бактерии или малоподвижные организмы. | Они успешно разрушаются при снижении температуры тела. Локализуются они в носоглотке и на оболочках головного мозга. |
| Пневмококковые инфекции. | Для них характерны болезненные восприятия в области груди, боязнь света, частая дезориентация в пространстве. |
Чтобы определить тот или иной вид диплококка, приходя к доктору, все женщины должны в точности описывать свои ощущения, процесс мочеиспускания, присутствии необычных выделений и не свойственных беспокойств.
Опираясь на ваше самочувствие, доктор сможет вовремя назначить необходимые анализы. К таким анализам относится сдача мочи и мазок. Сам мазок берется из уретры, влагалища и околоматочного пространства.
Заражение бактериями происходит по следующим причинам:
- Элементарное несоблюдение собственной гигиены;
- Применение антибиотиков без назначения лечащего врача и спринцевание без надобности;
- Начало половой жизни в раннем возрасте;
- Тесное синтетическое белье (очень близко граничит с анальным отверстием и является совершенным переносчиком бактерий во влагалище);
- Незащищенные половые акты с венерическим больным партнером;
- Проблемы с гормональным балансом;
- Частые спринцевания (многие считают процедуру полезной, однако она вымывает все полезные вещества и приводит к сильному раздражению в слизистой влагалища);
- Ношение синтетического нижнего белья;
- Падение иммунитета в организме;
- Частая смена половых партнеров.
Наиболее часто обнаруживают диплококки в мазке у мужчин, служащие возбудителем гонореи. Этот вид передаётся половым путём. После заражения бактерия размещается в уретральном канале и только через пять дней даёт о себе знать.
Первые симптомы гонореи:
- Ощущения дискомфорта при испускании мочи;
- Выделения гноя из половых путей;
- Боли внизу живота;
- Слабость и недомогание.
Если не принять срочных мер, патогенный микроорганизм поражает всю мочеполовую систему, попадает в эпителиальный слой и слизистую оболочку. Через время распространяется на лимфатическую систему. У пациентов, которые страдают от гонореи, может развиться уретрит.
Бывают случаи носительства бактерий, то есть микроорганизмы не активны, процесс заболевания не развивается, тем не менее, мужчина заражен и может передать бациллу женщине во время незащищённого полового акта. Гонорея одинаково поражает представителей сильного и слабого пола.
Наличие диплококков в мазке у женщин свидетельствует о развитии патогенных процессов в микрофлоре.
Стадии патогенных микроорганизмов
Выделяют две формы бактерий: внутриклеточная и внеклеточная. Первый вариант – прогрессирующий, второй – покоящийся.
Нередко диплококки в мазке у женщин внеклеточной формы выявляют на плановом исследовании, что становится для слабого пола полной неожиданностью. В мазке они не образуют цепочек, в отличие от репродуцирующего типа, а располагаются единично.
Причины появления внеклеточных диплококков у женщин
Такое проявление может возникнуть у женщин, которые недостаточно следят за гигиеной половых органов, носят неудобное бельё из синтетических материалов, часто меняют интимных партнёров, вступая в незащищённые акты.
Также внеклеточную форму может вызвать длительный приём антибиотиков и частые спринцевания растворами антисептиков, вымывающими полезную среду микрофлоры.
Чем опасна внеклеточная форма?
Внеклеточные диплококки не развиваются и не растут. Они указывают на нарушение микрофлоры. Но при снижении местного иммунитета или в случае попадания в организм других бактерий внеклеточная форма переходит в активную стадию и провоцирует возникновение гонореи.
Диплококки — это бактерии сферической формы. Они относятся к семейству Lactobacteriaceae. Представляют собой организмы, соединенные попарно и в редких случаях образующие цепочки. Как известно, различают 2 вида бактерий — грамположительные и грамотрицательные. Диплококки относятся к обоим из них. В медицине выделяют более 80 типов диплококков.
Анализы при диплококках в мазке
Для диагностики используют микроскопию.
Мазок берут у мужчин из уретры.
У женщин также из половых путей.
Только урогенитальные мазки подходят для диагностики гонореи.
В анальных и оральных мазках может содержаться множество других диплококков.
Их можно перепутать с гонококками, что становится причиной ошибочного диагноза.
Первое, на что обращает внимание врач при микроскопическом исследовании мазка, это появление большого количества лейкоцитов.
При воспалительном процессе их больше 5-10 в поле зрения.
К тому же, количество лейкоцитов превышает число эпителиальных клеток.
Выявляются диплококки.
Задача врача состоит в том, чтобы идентифицировать их как гонококки по трем параметрам:
- форма;
- окрас;
- расположение.
На вид бактерии выглядят как зерна кофе.
Они расположены по двое и обращены вогнутыми сторонами внутрь.
По Граму гонококки окрашиваются отрицательно.
То есть, в розовый цвет.
Если же врач после окраски препарата по Граму видит фиолетовые шаровидные бактерии, то это другие диплококки.
Решающее значение имеет расположение бактерий.
При гонорее диплококки располагаются не только вне клеток, но и внутри них.
Они проникают внутрь лейкоцитов и эпителиоцитов.
Для других диплококков это не характерно.
Диагноз гонорея не ставится, если при микроскопическом исследовании препарата не обнаруживаются внутриклеточно расположенные бактерии.
Симптоматика патологии
Диплококк можно выявить только в лабораторных условиях при изучении мазка, взятого из уретрального канала. Наиболее часто пациенты обнаруживают у себя наличие инфекции при сдаче развернутого анализа. Отдельных пациентов врач самостоятельно отправляет на анализы, так как может заподозрить гонорейную инфекцию.
При любом виде патологии диплококк проявляется у мужчин в виде следующих симптомов:
- Сильный зуд в области уретрального канала;
- Болевые ощущения при опорожнении мочевого пузыря;
- Эрекции в ночное время, сопровождающиеся болью;
- Боль при половом контакте;
- Гнойные или желтоватые выделения из мочеиспускательного канала;
- Появление сильного неприятного запаха из уретрального канала.
Если мужчина обнаружил у себя хотя бы два из вышеперечисленных симптома, он должен посетить врача в ближайшее время.
Уретрит, вызванный диплококком
У многих пациентов, страдающих гонореей, развивается уретрит. Патология протекает в три этапа. На первом этапе у пациента происходит инфицирование передней стенки мочеиспускательного канала. Мужчина начинает испытывать жжение при опорожнении мочевого пузыря. Диплококк вызывает появление небольших слизистых выделений из мочевого канала.
На второй стадии уретрита у больного появляется покраснение и отечность головки полового члена. При пальпировании члена можно выявить уплотнение стенок мочеиспускательного канала. Выделения становятся обильными и приобретают неприятный гнилостный запах.
Третья стадия характеризуется переходом воспаления на заднюю стенку мочеиспускательного канала. У мужчины возникают сильные болевые ощущения при окончании мочеиспускания. Пациент испытывает постоянное ощущение неполной опорожненности мочевого пузыря.
Усугубить симптомы гонорейного уретрита пациент может самостоятельно. Многие мужчины не соблюдают правильный образ жизни. Следующие вредные привычки вызывают усиление уретрита:
- Прием алкогольных напитков;
- Употребление острых специй с пищей;
- Прерванный половой контакт или намеренно затянутый.
На первом этапе заболевания, пациенту необходимо полностью отказаться от приема алкоголя и соблюдать половой контакт.
Посев на диплококки
Более информативным исследованием является культуральный метод.
Он обладает самой высокой специфичностью среди всех методик.
А потому почти не дает ложноположительных результатов.
Именно посев используется в судебно-медицинской экспертизе, как самый точный метод.
Он позволяет дифференцировать различные виды диплококков.
Суть метода состоит в следующем:
1. Берется мазок.
2. Помещается в питательную среду.
3. Культивируется в оптимальных для бактерий условиях.
4. После роста колоний проводится идентификация микроорганизмов для точного установления их вида.
Показания для посева:
- обследование детей;
- контроль излеченности;
- обследование женщин (у них диплококки редко выявляются при микроскопии);
- подозрение на изолированные орофарингеальные или анальные формы гонореи;
- резистентность к терапии (для оценки чувствительности к антибиотикам);
- сохраняющиеся симптомы гонореи при отсутствии диплококков в мазке по данным микроскопии;
- сексуальное насилие.
Растут колонии около 24 часов.
Если через 3 суток они не появляются, результат посева считается отрицательным.
Идентификация проводится по морфологическим и биохимическим признакам.
Колонии гонококков выглядят так:
- выпуклые;
- прозрачные;
- серые;
- диаметром до 1 мм.
При дальнейшей инкубации в течение последующих суток они становятся плоскими, а также увеличиваются в размере до 3 мм.
Обычно трудностей с идентификацией гонококков не возникает, если биоматериал для посева взят с урогенитального тракта.
А вот если мазки брались из ануса или рта, могут вырасти на питательной среде и другие гонококки.
Они несколько отличаются по тинкториальным свойствам.
Колонии менингококков имеют голубой цвет.
Непатогенные нейссерии образуют белые колонии.
Тем не менее, такие показатели как размер, цвет, форма меняются, в зависимости от условий культивирования и состава питательной среды.
Поэтому данные показатели не могут быть определяющими при идентификации диплококков.
Необходимы дополнительные тесты.
Оцениваются сахаролитические свойства бактерий.
Применяется оксидазный тест.
Он помогает определить цитохром-С оксидазу.
Для этого наносят тетраметил-р-фенилендиамин в виде однопроцентного раствора на подозрительную колонию.
Если через несколько секунд появится синее окрашивание, реакция положительная.
Это означает, что данный фермент присутствует.
В случае положительного теста диагноз гонорея считается подтвержденным.
Идентификация вида бактерий может быть проведена путем оценки сахаролитических свойств.
Но для этого требуется выделения чистой культуры диплококков.
То есть, проводится пересеивание колонии на другую питательную среду, чтобы на ней не было других бактерий.
После этого проводятся ростозависимые или ростонезависимые тесты.
В последнее время чаще используются ростонезависимые тесты.
Они позволяют получить результат в течение нескольких часов.
Для этого используются коммерческие наборы.
В случае ферментации сахаров цвет среды меняется с красного на желтый.
Такой результат считается положительным.
Он свидетельствует о наличии гонококков в питательной среде.
Лечение
Инфекции, вызванные этим видом бактерий, относятся к трудноизлечимым, потому как они затрагивают несколько органов. Одним из методов лечения выступают физиопроцедуры. Их назначают при сильных выделениях из мочеиспускательного канала и значительном отеке. Процедура заключается во введении специальным шприцем в уретру или влагалище специального дезинфицирующего раствора, чаще на основе фурацилина. На фоне лечения необходимо придерживаться ряда правил:
- отказаться от алкоголя;
- не употреблять соленые и острые блюда;
- придерживаться рекомендованной врачом диеты;
- исключить половые отношения;
- не заниматься спортом.
При инфекции, вызванной любым видом данных бактерий, обязателен прием антибиотиков. В целом, среди лекарственных средств используют следующие группы:
- пенициллиновые препараты – Ампициллин, Бициллин-3, Метронидазол, Тинидазол;
- препараты сульфаниламидной группы – Бисептол;
- фторхинолоны – Абактал;
- препараты с лактобактериями – Лактобактерин, Бифидумбактерин;
- иммуностимулирующие средства – гоновакцина, содержащая неактивные формы гонококков;
- антисептические растворы – Мирамистин, Хлоргексидин.
Лекарство Бисептол используется при наличии аллергии на пенициллины. Хороший результат приносит Абактал. Хватает однократного приема дозы этого препарата в 600 мг. При хронической форме лечение длится 3 дня. Среди часто назначаемых препаратов при гонококковой инфекции выделяются следующие средства:
- Бисептол. Содержит ко-тримоксазол. Выпускается в форме таблеток и суспензии. Они показаны для лечения гонореи, пиелонефрита, уретрита, простатита, пиелита, венерической лимфогранулемы, эпидидимита. Бисептол принимают по 4 таблетки за раз. Между приемами должен соблюдаться интервал 6 часов. Лечебный курс состоит из 16 таблеток. При хронической форме инфекции дозу увеличивают до 20 штук. После лечения требуется снова сдать мазок. Плюсом Бисептола является его хорошая переносимость.
- Бициллин-3. Это комбинированное противомикробное средство с узкой антибактериальной активностью. Антибиотик является представителем пенициллинов – лекарств природного происхождения, которые продуцируются некоторыми видами плесени. Иначе препарат именуется бензилпенициллином. Он используется при скарлатине, рожистых поражениях, ревматизме, ангинах, раневых инфекциях, фрамбезии, сифилисе. При гонорее Бициллин-3 вводят в виде 3-5 инъекций с перерывом в 3 дня между ними. Курс лечения определяется характером заболевания. Преимущество в быстром наступлении терапевтического эффекта.
- Лактобактерин. Содержит живые лактобактерии. Обладает антибактериальной, иммуномодулирующей и нормализующей микрофлору активностью. Лактобактерин используется при гонорее, сальпингите, хламидиозе, урогенитальном герпесе, атопическом дерматозе, сальмонеллезе. Доза для взрослых составляет 5 доз 2-3 раза в день. Максимум за сутки – 15 доз. Плюс препарата – возможность применения на фоне антибиотикотерапии.
- Хлоргексидин. Содержит одноименное вещество, обладает антисептическим действием, преимущественно бактерицидным. Плюс – при местном применении не оказывает системного влияния на организм. Препарат показан при трихомониазе, генитальном герпесе, хламидиозе, гонорее, хламидиозе. Мужчины должны вводить по 2-3 мл средства в мочевой канал, а женщины – по 1-2 мл в мочевой канал и 5-10 мл во влагалище. Достоинство препарата в редком появлении побочных эффектов.
Что делать если в мазке появились диплококки
При обнаружении диплококков, если установлен диагноз гонорея, врачи сразу же назначают лечение.
Его основными целями являются:
- уничтожение бактерий – виновников воспалительного процесса;
- предотвращение распространения возбудителя в другие органы;
- предотвращение заражения контактных лиц;
- профилактика осложнений (абсцессов, генерализованной гонореи и т.д.);
- устранение симптомов заболевания.
Лечение должно проводиться под контролем венеролога.
Терапией гонококковой инфекции также занимаются гинекологи и урологи.
При обнаружении диплококков существует высокая вероятность того, что у этого же пациента имеются другие инфекции.
Они выявляются больше чем у половины больных.
Поэтому рекомендовано обследование на сопутствующие ЗППП.
В противном случае лечение может быть неэффективным.
Клиническое выздоровление после курса антибиотикотерапии часто не наступает по причине наличие других половых инфекций.
У пациента берут мазок из уретры.
Его исследуют методом ПЦР на хламидиоз, трихомониаз.
Берут кровь на ВИЧ и сифилис.
Обязательно подлежат обследованию и лечению все контактные лица.
Партнеры пациента должны быть уведомлены о наличии у него венерического заболевания.
Они приходят в клинику и тоже обследуются на диплококки.
Если гонорея не обнаружена в мазке, проводится ПЦР.
В случае недавнего полового контакта с носителем гонококковой инфекции проводится превентивное лечение.
Только если все партнеры одновременно излечиваются, прерывается эпидемиологическая цепочка заболевания.
В противном случае происходит реинфицирование, и пациент вскоре может вернуться в клинику с теми же симптомами.
Гонорея: причины и разновидности
Если у пациента был обнаружен данный возбудитель, то это говорит о наличии у него определенного заболевания. Конкретная патология зависит от вида обнаруженного кокка. Самым неприятным считается гонококк, вызывающий болезни мочеполовой системы. У женщин и мужчин они вызывают как ряд общих патологий, так и характерных для одного пола. Жизни же пациента угрожают менингококки и пневмококки, потому как они поражают головной и спинной мозг, дыхательную систему.
У женщин
Каждая бактерия вызывает определенные заболевания. Гонококки провоцируют развитие гонореи. Эта инфекция передается половым путем и у женщин длительно может протекать без каких-либо симптомов. Гонорея поражает мочеполовые органы. Гонококковая инфекция может протекать в виде:
- Гонококкового цервицита. Представляет собой воспаление шейки матки, которое сопровождается ноющими болями внизу живота, выделениями с гноем, высокой температурой и ухудшением общего состояния.
- Аноректальной гонореи. Поражает прямую кишку, вызывает зуд заднего прохода, отечность слизистой, трещины и гнойные выделения.
- Гонококкового вагинита. Опасная инфекция, которая при хронитизации приводит к бесплодию. На нее указывают жжение и зуд половых органов, пенистые выделения, общая интоксикация.
Иногда гонококк диагностируется у беременных. В таком случае необходимо немедленно начинать лечение, чтобы избежать развития патологий у плода. У новорожденных высок риск заразиться при прохождении через родовые пути или внутриутробно. В первом случае инфекция проявляется гонорейным вульвовагинитом или гнойным конъюнктивитом. При обнаружении менингококка у пациента диагностируют:
- менингококцемию;
- менингит;
- артрит, эндокардит, иридоциклит.
Указанные болезни чаще отмечаются в возрасте до 30 лет. Много людей погибает и от пневмококковых инфекций. Они распространяются воздушно-капельным путем, часто напоминают ОРЗ. Риск заболеваемости особенно высок у детей, пожилых и женщин с хроническими патологиями. Список распространенных инфекций включает:
- пневмонию;
- пневмококковый отит;
- пневмококковый менингит;
- синусит.
В мазке у мужчин уретрит
Диплококки у мужчин вызывают практически те же заболевания, что и у женщин. Из-за менингококков и пневмококков развиваются разные формы менингита и пневмонии. Гонорея же, вызываемая гонококками, чаще диагностируется у мужчин, как и гонорейный уретрит. Инкубационный период первого заболевания длится 3-5 дней, но у некоторых пациентов затягивается до 3 недель.
Заразиться заболеванием можно только при половом контакте с носителем. По этой причине риск выше у тех, кто ведет беспорядочную половую жизнь. Гонорея бывает свежей или хронической. Первая разделяется еще на несколько подтипов в зависимости от характера симптомов:
- Острая гонорея. Сопровождается выделениями из уретры и жжением в ее области.
- Подострая гонорея. Объем выделений становится больше, они переходят в гнойные. Некоторые пациенты отмечают неприятный запах. Постепенно симптомы становятся менее выраженными.
- Торпидная гонорея. Сопровождается теми же симптомами, но их выраженность не настолько яркая. Иногда признаки и вовсе отсутствуют.
У ребенка
Вероятность заражения детей гонококком очень мала, поскольку они еще не ведут половую жизнь. Хотя ряд специалистов имеют мнение, что эта бактерия способна распространяться бытовым путем. По этой причине ребенок может заразиться, если в семье кто-то болеет гонореей. Более опасным для детей является менингококк. Он способен вызвать смерть буквально за несколько дней. Заражение происходит воздушно-капельным путем.
Менингококк поражает носоглотку, а затем попадает в мозговые оболочки. При обнаружении этих бактерий в мазке требуется немедленное лечение, ведь риск смерти очень высок. Поражать организм детей могут и пневмококки. Особенности их распространения:
- бактерия проникает в легкие ребенка и вызывает их поражение, особенно легко это происходит на фоне анемии и авитаминоза;
- при возрастании числа бактерий их обнаруживают и в мазке с половых органов;
- пневмококковые инфекции особенно распространены на фоне ОРВИ.
Путь заражения зависит от патогенности бактерии:
- Внутриклеточная гонококковая бактерия проникает в организм через незащищенный секс, при совместном использовании индивидуальных предметов и внутриутробно. Гонорея является одним из самых неприятных заболеваний, которое при отсутствии лечения может повлечь неприятные последствия.
- Менингококковая бактерия является патогенной, и может проявиться в мазке. Основной путь заражения воздушно-капельный и бытовой. Инфекция поражает оболочку головного мозга и слизистую носоглотки. Без соответствующего лечения могут возникнуть серьезные осложнения с необратимыми процессами.
- Пневмококковая бактерия становится частой причиной пневмонии, особенно у маленьких детей и пожилых людей. Передается пневмококк воздушно-капельным и контактно-бытовым путем. При наличии пневмококка, у пациента могут быть обнаружены вне- и внутриклеточные диплококки.
Пройти тест на наличие диплококков
Диплококки внеклеточные в мазке – это бактерии, которые относятся к семейству Lactobacteriaceae. Многие из них обладают сферической формой, но в ходе исследования могут быть обнаружены бактерии бобовидной формы. Они сливаются по парам и могут выстраиваться в цепочку. У женщин могут быть обнаружены грамотрицательные и грамположительные диплококки в мазке. Они могут быть более 80 видов. Чаще всего причины диплококков в мазке заключаются в наличие воспалении легких, менингите и гонореи.
Такие микроорганизмы могут быть нескольких видов, самыми распространенными являются возбудители венерического недуга – гонорея. Диплококки в мазке у мужчин приводят к формированию гнойных выделений, нарушению мочеиспусканию.
Гонококки – это самые патогенные возбудители данного вида. Для такой патологии характерно обнаружение микроорганизмов и большое количество лейкоцитов.
Гонококк очень чувствителен к таким препаратам, как:
- бензилпенициллин;
- тетрациклин;
- эритромицин;
- доксициклин;
- цефалоспорин;
- бисептол.
К такой форме диплококков не вырабатывается иммунитет. Срочная профилактика состоит в местном использовании биглюконата хлоргексидина после полового контакта. Постоянная профилактика предусматривает применение презерватива.
Если в мазке обнаружены диплококки, то они могут носить не такой патогенный характер, но уделять вниманию возникшей патологии все равно необходимо. Очень важно бороться не только с бактериями, но и последствиями несвоевременной терапии. Лечение диплококков в мазке должно осуществляться только лечащим врачом, самолечение приведет с серьезными осложнениям. Схема терапии может назначаться лишь лечащим врачом.
Итак, гонококки — наиболее распространенная разновидность диплококков. Гонорея тоже является наиболее распространенным венерическим заболеванием, которое диагностируется у мужчин. Однако это заболевание не сугубо мужское — ему подвержены и женщины. Инкубационный период заболевания составляет от 3 до 5 дней, однако может затянуться и до 3 недель.
Причина заражения гонореей всегда только одна — половой контакт с носителем. Иными путями заболевание не передается. Как правило, подвержены ему больше мужчины, которые ведут беспорядочную половую жизнь и имеют незащищенные половые контакты с непостоянным партнером. При этом в первую очередь поражается уретра.
Затем возбудитель переходит на слизистые оболочки органов мочеполовой системы, проникает в лимфатическую систему и поражает соединительную ткань. Распространившись по эпителию, возбудитель провоцирует развитие воспалительного процесса. В свою очередь, воспаление сопровождается отеком, гиперемией, нагноением, инфильтрацией. В конце происходит разрушение самого эпителия. В редких случаях гонококк может попасть в кровеносную систему.
Разновидности гонореи у мужчин
Гонорею принято разделять на 2 типа: свежую и хроническую. Свежую гонорею разделяют еще на 3 вида:
- Острая гонорея. Наиболее характерные симптомы — жжение и выделения из уретры.
- Подострая гонорея. Симптомы усиливаются: выделения становятся более обильными, переходя в гнойные. Возможно появление неприятного запаха, характерного для этого заболевания. Затем выраженность симптомов несколько снижается.
- Торпидная гонорея. Для этого типа гонореи характерны те же симптомы (выделения, зуд и др.), но они очень слабо выражены. Кроме того, какая-либо симптоматика может и вовсе отсутствовать.
Хроническая гонорея никак себя не проявляет. Она не сопровождается такими симптомами, как свежая гонорея. Максимум, что может наблюдаться, — это незначительные выделения из уретры, но более ярко выраженных признаков не наблюдается. В хроническую стадию болезнь переходит в том случае, если не было назначено лечение, когда она находилась в свежей стадии.
Симптомы гонореи у мужчин
Гонорею можно выявить при помощи мазка. В некоторых случаях она выявляется случайно, если мужчина сдает мазок на какую-либо другую бактерию или инфекцию. Однако мужчину могут направить специально сдавать мазок на гонорею, если имеются подозрения на заболевание. Гонококк поражает эпителий органов мочеполовой системы (чаще всего цилиндрический, но иногда и плоский), конъюнктивы.
- ощущение рези в процессе опорожнения мочевого пузыря;
- серозно-гнойные выделения из уретры;
- ночные эрекции, сопровождающиеся болевыми ощущениями;
- отек головки пениса;
- выделения желтоватого оттенка из мочеиспускательного канала;
- болезненные ощущения при акте мочеиспускания.
Кроме симптомов, которыми сопровождается гонорея в любом случае, выделяют еще ряд симптомов, которые могут наблюдаться у некоторых мужчин:
- воспалительный процесс в области прямой кишки;
- воспаление слизистой оболочки горла;
- воспаление глаз.
Как лечить диплококки в мазке
Основная цель терапии – это эрадикация диплококков.
Назначаются препараты, которые уничтожают этих бактерий.
В основном используется цефтриаксон.
Этот препарат угнетает транспептидазу.
Тем самым он нарушает синтез мукополисахарида – компонента клеточной стенки диплококков.
Препарат стабилен в присутствии бета-лактамаз.
Поэтому к нему редко встречаются случаи резистентности у гонококков.
Вводится препарат внутримышечно.
Пероральных форм не существует, так как цефтриаксон почти не всасывается в желудочно-кишечном тракте.
Максимальная концентрация в плазме крови достигается спустя 3 часа после введения препарата.
Используют его 1 раз в сутки, по 0,25 г.
Одного укола достаточно для лечения неосложненных форм:
- урогенитальной;
- анальной;
- орофарингеальной гонореи.
Если гонококки обнаруживаются в конъюнктиве глаза, цефтриаксон назначают в разовой дозе 1 грамм.
При отсутствии осложнений возможно лечение гонореи пероральными цефалоспоринами.
Используется цефиксим.
Его назначают в разовой дозе 400 мг.
Осложненные или хронические формы гонококковой инфекции требуют более длительной терапии.
Используемые дозировки антибиотиков выше.
Назначают цефтриаксон по 0,5 грамм в сутки.
Инъекции делают внутримышечно или внутривенно.
Курс лечения продолжается около 2 недель.
Его длительность зависит от тяжести состояния пациента, распространенности инфекции.
В некоторых случаях проводится лечение в условиях стационара.
Госпитализация необходима в таких случаях:
- системные проявления заболевания;
- угроза прерывания беременности у женщин;
- необходимость проведения лапароскопического или другого инвазивного исследования.
В условиях стационара может применяться вместо цефтриаксона цефотаксим.
Его назначают по 1 грамму внутривенно, 3 раза в сутки.
Когда не нужно лечить
В случае выявленного дисбактериоза, необходимо в первую очередь восстановить нормальную микрофлору влагалища. Для этого назначаются лакто- и бифидобактерии, корректируется рацион питания (должны преобладать кисломолочные продукты), комплекс витаминов.
Немаловажно придерживаться здорового образа жизни, а именно:
- Отказаться от употребления спиртных напитков.
- Исключить соленую и острую пищу.
- Воздержаться от половых контактов.
- Избегать чрезмерных физических нагрузок.
Медикаментозная терапия будет зависеть от вида выделенного возбудителя. Если в мазке были выявлены пневмо-, менинго- или гонококки – обязательно назначаются антибактериальные препараты.
Предпочтение отдают:
- Антибиотикам пенициллинового ряда – Ампициллину, Метронидазолу.
- Препаратам из сульфаниламидной группы – Бисептолу.
- Фторхинолонам – Абакталу.
Однако стоит помнить о том, что некоторые возбудители могут быть нечувствительны к некоторым антибиотикам. Например, менингококк устойчив к действию сульфамидов, Ристомицину.
Помимо антибиотиков используют антисептики (Мирамистин, Хлоргексидин), а также иммуностимулирующие препараты.
Медикаментозную терапию следует применять строго по назначению лечащего врача.
Процедура проводится в тех случаях, когда длительный дисбактериоз привел к заболеваниям, которые осложнились бесплодием. Препарат вводится на 19–22 день цикла, а после менструации женщины начинают принимать гормоны.
Процедура является достаточно дорогостоящей. Приживаемость эмбрионов высокая, однако, все равно всегда остается незначительный риск гибели всех зародышей, что необходимо учитывать.
Антибактериальная терапия не потребуется, если бактерия является внеклеточной, а также при условии отсутствия симптоматики.
Но, в данном случае будут рекомендованы препарата на основе Lactobacillus и Bifidobacterium для нормализации влагалищной микрофлоры.
Контрольные анализы на диплококки
После курса лечения обязательно выполняется лабораторный контроль.
Необходимо убедиться, что диплококков в мазке больше нет.
Анализы сдают на 2 день после окончания антибиотикотерапии, а затем ещё раз через 14 дней.
Лабораторный контроль может проводиться при помощи ПЦР или бак посева.
Микроскопическое исследование не обладает достаточной чувствительностью, чтобы точно подтвердить излеченность.
Потому что в микроскоп диплококки выявляются, только если их много, и симптомы заболевания ярко выражены.
При малом количестве гонококков они не попадают в поле зрения.
Если ПЦР дает негативный результат, человек считается излечившимся.
В случае, когда исследование положительное, необходимо повторное лечение диплококков в мазке.
Возможные причины отсутствия эффекта:
- неправильный прием пациентом препаратов (если он лечился в домашних условиях);
- формирование резистентности к применяемому антибиотику и диплококков;
- повторное заражение (если не пролечен половой партнер).
Для повторного лечения диплококков в мазке у женщин назначают препараты других фармакологических групп.
Может применяться спектиномицин.
Его назначают по 2 грамма внутримышечно, 2 раза в день.
Оптимальной тактикой в случае положительного результата контрольного исследования на диплококки является бактериологический посев.
В ходе исследования определяется чувствительность гонококка к различным антибактериальным препаратам.
Это позволяет врачу подобрать тот антибиотик, который с высокой вероятностью приведет к эрадикации возбудителя.
Другие заболевания, связанные с диплококками
Neisseria meningitidis (менингококк)
Neisseria meningitidis — это грамотрицательная бактерия, которая колонизирует носоглотку человека. Она имеет 13 серотипов и является основной причиной бактериального менингита и сепсиса (заражение крови).
Патогенность бактерии заключается в том, что капсула, которой окружена нейссерия, сопротивляется фагоцитозу человеческого тела.
Заставляет ее размножаться в организме, вызывая инфекционные процессы. В основном вызывает воспаление лобных пазух, бронхит, плеврит, сепсис и т. д.
Менингококк обычно заражает детей и подростков с ослабленным иммунитетом. Как правило, болезнь начинается через день-два после проникновения патогена в организм.
Бактерия локализуется в верхних дыхательных путях, не вызывая никаких симптомов. Основной путь передачи – воздушно-капельный.
Существует несколько видов менингококковой инфекции, диагностируемых в 90% случаев.
Оба заболевания потенциально опасны для жизни:
Самый известный тип менингококковой инфекции. Бактерии атакуют мозговые оболочки, вызывая их воспаление.
Болезнь проявляется неврологическими симптомами. Такими как острая головная боль, скованность в шее и неспособность согнуть голову вперед.
Данные симптомы сопровождаются лихорадкой, тошнотой и рвотой.
Летальный исход от инфекции диагностируется только в 10% случаев. В некоторых случаях менингококк может провоцировать суставные инфекции и воспаление миокарда.
Большинство менингококковых инфекций встречаются в более теплых районах, в основном зимой и весной.
- Менингококковый сепсис
Менингококковый сепсис является чрезвычайно тяжелым заболеванием с уровнем смертности около 25%. Термин сепсис («отравление крови») означает распространение бактерий по всему телу через кровеносную систему. Meningococcus способен вызвать наиболее тяжелое септическое состояние из-за обильно продуцируемого вещества, называемого липополисахаридом.
Вещество выделяется в больших количествах в кровь. Вызывает сильный иммунный ответ на фоне чрезмерного продуцирования патогенов. Как следствие, наблюдается острое нарушение кровообращения.
Организм пытается предотвратить распространение инфекционного агента. Но вместе с тем не нарушить работу сердца, головного мозга и надпочечников.
Как следствие, другие органы страдают от дефицита кислорода и питательных веществ. Наблюдается острое нарушение их функционирования. В первую очередь, страдает печень и почки.
Менингококковый сепсис сопровождается понижением артериального давления, увеличением сердечного ритма, частоты дыхания, бледностью и нарушением мочеиспускания.
Тяжелая инфекция может привести к опасной гипотензии (шоку), склонности к кровотечениям и дисфункции нескольких органов ((например, печени и почек) (отказ)). От 10 до 15% пациентов с менингитом умирают даже после лечения.
Среди выздоравливающих людей 10-20% будут иметь серьезные осложнения. Такие как постоянная глухота, умственная отсталость, в тяжелых случаях может потребоваться ампутация пальцев ног, рук. Нередко инфекция протекает медленно и вызывает умеренно прогрессирующие симптомы, к примеру, незначительное повышение температуры тела.
Основное лечение: внутривенные антибиотики (обычно пенициллин) и внутривенная регидратация (восстановление водного баланса). Может потребоваться использование кортикостероидов.
Гонококк (Neisseria gonorrhoeae)
Neisseria gonorrhoeae является одной из наиболее распространенных инфекций, передаваемых половым путем (ИППП).
Это исключительно человеческий патоген, который уклоняется от иммунной системы хозяина посредством множества механизмов.
N. gonorrhoeae подавляет способность антигенпредставляющих клеток индуцировать пролиферацию CD4 Т-клеток.
Гонококк имеет вид неподвижного парного кокка, половинки которого визуально напоминают кофейное зерно. При развитии неблагоприятных условий (воздействие бактериостатическими препаратами), бактерия трансформируется и изменяет собственные свойства. Гонококк отличается повышенной устойчивостью в организме человека, но во внешней среде быстро погибает.
Neisseria gonorrhoeae передается путем сексуального контакта, где не были использованы защитные методы контрацепции. У некоторых пациентов заболевание протекает в бессимптомной форме, данное явление чаще встречается у женщин.
Основная локализация гонококков и их паразитирование наблюдается на слизистой уретрального канала, шейки матки, нижней части прямой кишки, конъюнктивы. Инфекция склонна протекать совместно с другими типами ЗППП.
Часто при наличии гонореи диагностируется хламидиоз, сифилис, трихомониаз. Терапия инфекционного процесса заключается в использовании антибактериальных препаратов. Наиболее эффективными считаются средства цефалоспоринового ряда.
Пневмококк (Streptococcus pneumoniae)
Пневмококки представляют собой грамположительные бактерии рода Streptococcus. Принадлежат к семейству Lactobacillales и окружены полисахаридной капсулой. Структура капсулярных полисахаридов имеет решающее значение для серотипа и антигенности. Капсула также отвечает за патогенность возбудителя и защищает его от фагоцитоза.
Антитела против патогена обычно появляются через 5-8 дней после заражения и направлены против капсулярных полисахаридов. Тем не менее, иммунный ответ зависит от В-клеток. Это объясняет, почему дети не развивают специфический для серотипов иммунитет в первые два года жизни. Поэтому подвергаются особому риску.
Морфологически пневмококки являются диплококками, поскольку бактерии расположены парами.
Пневмококк является одной из наиболее распространенных бактериальных причин пневмонии. Бактерии обычно инфицируют дыхательные пути, которые ранее были ослаблены местной вирусной инфекцией. Симптомы включают высокую температуру тела, кашель с отхаркиванием слизи и гноя, боль в груди и одышку.
Pneumococcus может распространяться на миндалины и вызывать классический тонзиллит. Болезнь сопровождается высокой температурой, недомоганием и выраженной болью в горле. Боль обычно усиливается при глотании, миндалины увеличены, красные и покрыты беловатым налетом.
Пневмококк является распространенной причиной инфекции среднего уха. Заболевание проявляется сильной болью в ухе, лихорадкой, недомоганием и иногда снижение слуха.
В качестве заболевания особенно опасен менингит. При этом пневмококки после менингококков представляют собой вторую по распространенности причину бактериального менингита. Заболевание часто встречается у детей в результате инфекции верхних дыхательных путей.
Симптомы зависят от возраста детей. Пневмококковая болезнь лечится антибиотиками, такими как цефалоспорины.
При выявлении диплококков в мазке обращайтесь к автору этой статьи – венерологу в Москве с многолетним опытом работы.
Профилактика диплококка в мазке
Чтобы в ваших мазках никогда не было диплококков, необходимо сделать следующее:
- ограничить количество половых партнеров;
- не заниматься сексом с людьми, у которых имеются признаки воспаления мочеполовых органов;
- всегда использовать презерватив.
После секса можно делать экстренную профилактику.
Для этого необходимо обработать гениталии Мирамистином.
Его необходимо ввести в уретру, влагалище.
Если был анальный или оральный секс – прополоскать горло и ввести в прямую кишку.
Делать это нужно в течение 2 часов после интимного контакта.
Если вы не уложились в это время, желательно обратиться к врачу и получить превентивную терапию.
Оно состоит в промывании уретры катетером.
Вводятся антисептические растворы на основе ионов серебра.
Выполняется также инъекция цефтриаксона.
Небольшая однократно введенная доза антибиотика позволяет предотвратить заражение.
Диагностика
Подтвердить определенный диагноз только по симптоматике, которая наблюдается у пациента, сложно. По этой причине при подозрении на гонококковую инфекцию назначают ряд лабораторных исследований, включая:
- посев на питательную среду;
- общий анализ мочи;
- бактериологический посев.
Основным методом диагностики является мазок из уретры или влагалища. Чтобы получить максимально точный результат, необходимо отказаться от интимных отношений за 2 дня до проведения анализа. Антибиотики должны быть исключены еще раньше – за неделю до посева. В день перед самим анализом нужно отказаться от интимной гигиены, а за 2-3 часа до него – не опорожнять мочевой пузырь. Подмыть промежности можно только накануне взятия мазка. Женщинам нельзя пользоваться вагинальными суппозиториями в течение 2 дней до проведения анализа.